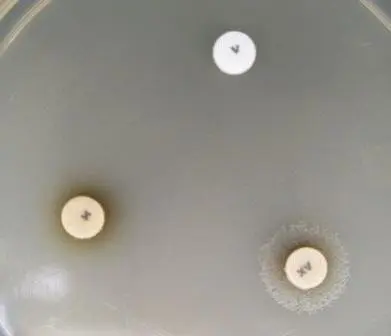
This strain is presumptively Haemophilus influenzae as it has grown only around the disk containing both XV factor. - This strain is presumptivelyHaemophilus influenzaeas it has grown only around the disk containing both XV factor.

X factor (hemin) and V factor (nicotinamide-adenine-dinucleotide, NAD) requirement tests are done to identify and differentiate Haemophilus spp. especially identification of Haemophilus influenzae, which causes deadly diseases like meningitis, and pneumonia, among others.
In blood agar, RBCs release NAD+ (factor V) released by the RBC may be present in the medium and are available to the bacteria, but the amount may not be sufficient for the growth ofHaemophilus influenzae. The hemin (factor X) is bound to RBCs and is not released into the medium unless the cells are lysed by other bacteria such asStaphylococcus aureusor via heat as in chocolate agar. The lysis of RBCs increased the level of factor V and also factor X, thus facilitating the growth of bacteria that needs X and V factors for growth.
Haemophilus sppis small, pleomorphic, gram-negative bacilli or coccobacilli with random arrangements. H. influenzae is a fastidious organism that grows best at 35-37°C with ~5% CO2 (or in a candle-jar) and requires both X factor and V factor for growth. H. influenzae cannot grow on an unsupplemented Blood Agar plate or any other general-purpose medium such as Trypticase Soy Agar, or Nutrient Agar. Blood agar contains free V, but not X factor, whereas general purpose medium lacks both X and V.
Haemophilus ducreyi, the causative agent of sexually transmitted infections (genital chancre), requires factor X for its growth. In contrast, Haemophilus parainfluenzae (causative agent of pneumonia and endocarditis) requires only factor V and can grow on blood agar.
Mnemonic to remember growth factor requirements of most common pathogenic species of HaemophilusHaemophilusparainfluenzaerequires factor V (pmeanspannch=V)Haemophilusducreyirequires factor X(d–dus means X)Haemophilus influenzaerequires factor X and V
H. influenzae can be grown in a blood agar plate previously streaked with beta-hemolytic Staphylococcus aureus. X factor, or hemin, is provided by the lysed sheep RBCs surrounding the Staphylococcusstreak, while the staphylococci provide the V factor or NAD. These factors enable the tiny dewdrop colonies of Haemophilus to grow adjacent to the Staphylococcusstreak, a phenomenon known as satellitism.

Chocolate Agar (heat-lysed sheep or horse blood agar) plate is the standard medium to grow H. influenza.
Growth occurs on a Chocolate Agar because NAD is released from the RBCs during the heating process of chocolate agar preparation (the heating process also inactivates growth inhibitors). The hemin within intact RBCs is not accessible to the bacteria unless the erythrocytes are lysed by other bacteria or by heating the medium to make chocolate agar.
Growth factor requirements can be determined using the principles of agar diffusion with paper disks or strips containing X, V, and XV factors.
Procedure:
- Prepare a heavy suspension of cells (1 McFarland turbidity standard) of the organism in saline.
Note: It is important not to carry over any X-factor or V factor contained in the medium that the organism is taken from.
- Dip a sterile swab into the organism suspension. Roll the swab over the entire surface of a trypticase soy-agar plate.
- Place the X, V, and XV factor disks on the agar surface. If using separate disks, place them at least 4 to 5 cm apart.
- Carefully invert the plate and incubate overnight at 35°C in place it in a CO2-incubator or candle extinction jar.
Expected Results
H. influenzae will grow only around the XV disk (i.e., the disk containing both X and V factors).
| Growth Around | Inference | |||
|---|---|---|---|---|
| X disk | V disk | XV disk | Entire Agar surface | |
| No | No | Yes | No | Requirement for both X and V factor |
| No | Yes | Yes | No | Requirement for V factor |
| Yes | Yes | Yes | Yes | No requirement for either X or V factor |
X and VFactorRequirement

| Organism | X Factor | V Factor |
|---|---|---|
| Haemophilus influenzae | + | + |
| H. influenzae biotype aegyptius | + | + |
| H. haemolyticus | + | + |
| H. parahaemolyticus | – | + |
| H. parainfluenzae | – | + |
| H. paraphrophilus | – | + |
| H. segnis | – | + |
| H. ducreyi | + | – |
| H. aphrophilus | – | – |
Quality Control
- Positive:
Haemophilus influenzae will show a halo of growth around XV disk; the rest of the agar surface will show no growth. Haemophilus parainfluenzae will show a halo of growth around XV and V disks.
- Negative
Haemophilus aphrophilus will grow over the entire surface of the plate. Neither X, nor V, nor XV factors are necessary for growth.
NOTE
H. haemolyticus also shows similar results (only grows around the disk containing hemin and NAD). HaemophilusID Quad plates can be performed to differentiate between these two isolates. H. haemolyticus gives β hemolysis when grown on media containing horse blood, but H. influenzae grows on such media but does not hemolyze the horse blood cells.
References and further reading:
- Laboratory Methods for the Diagnosis of Meningitis caused by Neisseria meningitidis, Streptococcus pneumoniae,andHaemophilus influenzae (Images and flow chart are taken from this manual)
- Musher DM. Haemophilus Species. In: Baron S, editor. Medical Microbiology. 4th edition. Galveston (TX): University of Texas Medical Branch at Galveston; 1996. Chapter 30. Available from: https://www.ncbi.nlm.nih.gov/books/NBK8458/